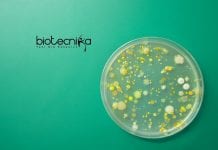
Kerry Quality Specialist Job – Life Science & Microbiology Apply Kerry Quality Specialist Job

Research Scholar Job at Presidency University l MSc Biological Science Candidates Attend the Walk-In-Interview
Research Scholar Job at Presidency University l MSc Biological Science Candidates Attend the Walk-In-Interview
Presidency University, Kolkata, is inviting applications for a Research Scholar position...
Jubilant Biosys Hiring Senior Scientist in Immuno-Oncology (In Vivo) – Apply in Bengaluru!
Senior Research Scientist Job – Immuno-Oncology, Bengaluru – Apply Now
Jubilant Biosys is inviting applications for the role of Senior Research Scientist / Team Lead...
Project Associate Job at CSIR-NEERI l MSc Zoology Candidates Attend the Walk-In
Project Associate Job at CSIR-NEERI l MSc Zoology/Environmental Science Candidates Attend the Walk-in-Interview
CSIR-National Environmental Engineering Research Institute (NEERI) invites applications for the position of...
Microbiology Project Assistant Opportunity at MACS ARI Pune, Apply Now!
Microbiology Project Assistant Opportunity - at MACS ARI Pune, Apply Now!
ADVT/RecT/04/SP-321/2025-26
The Agharkar Research Institute (ARI), Pune, invites applications from qualified candidates for two Project...
JRF Job Amity University With Salary Rs 48,100/month, Apply Now!
JRF Job Amity University - with salary Rs 48,100/month Apply Now!
Amity University Uttar Pradesh, Noida invites applications for a Junior Research Fellow (JRF) position...
Join Dr. Reddy’s Bio Assay Team – MSc, BTech & MTech Biotech Apply
Biotech Jobs at Dr Reddy's Labs - MSc, BTech & MTech Biochem/ Microbiology Apply
Looking for an exciting career opportunity in the biologics and biosimilars...
What Is Medical Coding? A Beginner’s Guide to the Healthcare Backbone
Importance and Career Opportunities in Medical Coding
In today’s fast-moving world healthcare industry, accurate documentation as well as billing are essential to ensure healthcare operations...
From Bengaluru to Boston: How a $400K Indo–US Collaboration Is Using AI Medicine for...
From Bengaluru to Boston: How a $400K Indo–US Collaboration Is Using AI Medicine for Tomorrow’s Viruses!
In an era where the next pandemic could emerge...
Biotecnika Times Newsletter 20.06.2025 – UPSC, Intas Walk-In, Eversana, Serotonin Labs Hiring + Admissions...
BioTecNika Info Labs Pvt Ltd | Established 2006 | For you
BioTecNika Times
ONLINE | BANGALORE
18 Years of Service dedicated to Bio Professionals & Biotech Industry
///////////////////////////////////////////////////////////////////////////////////////////////////////////////////////
All India Toll Free Ph:...
Bioinformatics Jobs at Serotonin Labs – Earn Up to Rs. 8 LPA, Apply at...
Bioinformatics Jobs at Serotonin Labs - Earn Up to Rs. 8 LPA, Apply at Biotecnika
Job Title: Bioinformatics
Company Name: Serotonin Labs
Location: Bangalore, India
Experience: 2–3 years
CTC:...
Govt UPSC Biochem/Microbiology Jobs For MSc – Work in BCG Vaccine Laboratory
UPSC latest notification 2025 - Biochem & Microbiology Jobs
Want to work at the intersection of public health, research, and vaccine science? The BCG Vaccine...
Bioinformatics/Molecular Biology Project Jobs at CSIR-CCMB – Apply Online
Bioinformatics/Molecular Biology Project Jobs at CSIR-CCMB - Apply Online
CSIR-CENTRE FOR CELLULAR AND MOLECULAR BIOLOGYUppal Road, Habsiguda, Hyderabd 500 007 TelanganaNotification Number: 0625/B
Date: 19.06.2025
Applications...
IQVIA Regulatory Affairs Jobs For BSc/MSc Life Sciences – Apply Online
IQVIA Regulatory Affairs Jobs For BSc/MSc Life Sciences - Apply Online
Regulatory Affairs Specialist
Bengaluru, India
Full time
R1489629
Office-based
Job Description
Job Overview
Individual contributor who is fully proficient in applying...
Brik Oven Hiring Food Technologist – Your Next Delicious Career Move
Food Technologist Jobs Bengaluru - Brik Oven Hiring
Food Technologist
1-10
Doddaballapura - CK
Full-Time
Job Summary:
We are seeking a skilled and detail-oriented Food Technologist to join our central...
Manipal University Jaipur Admissions 2025-26 Open in DST- FIST Supported Department of Biosciences –...
Manipal University Jaipur Admissions 2025-26 Open - Applications Invited Online
Manipal University Jaipur Admissions 2025-26 Open in DST- FIST Supported Department of Biosciences - Online...